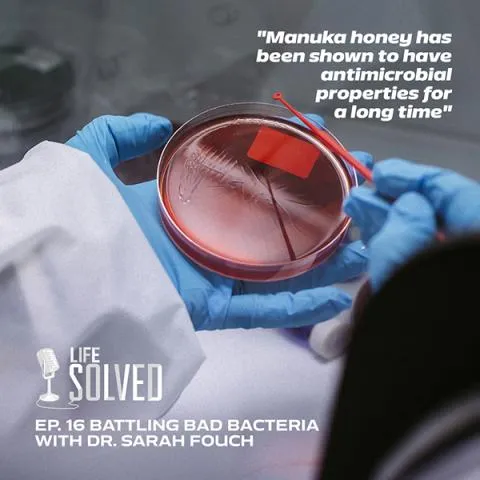

Manuka honey, used in catheters, is proving effective in tackling infection
External linkPatients undergoing hospital treatment can face a challenge to recovery due to bacteria resistant to antibiotics. Read more.
Patients undergoing hospital treatment can face a challenge to recovery due to bacteria resistant to antibiotics. Read more.